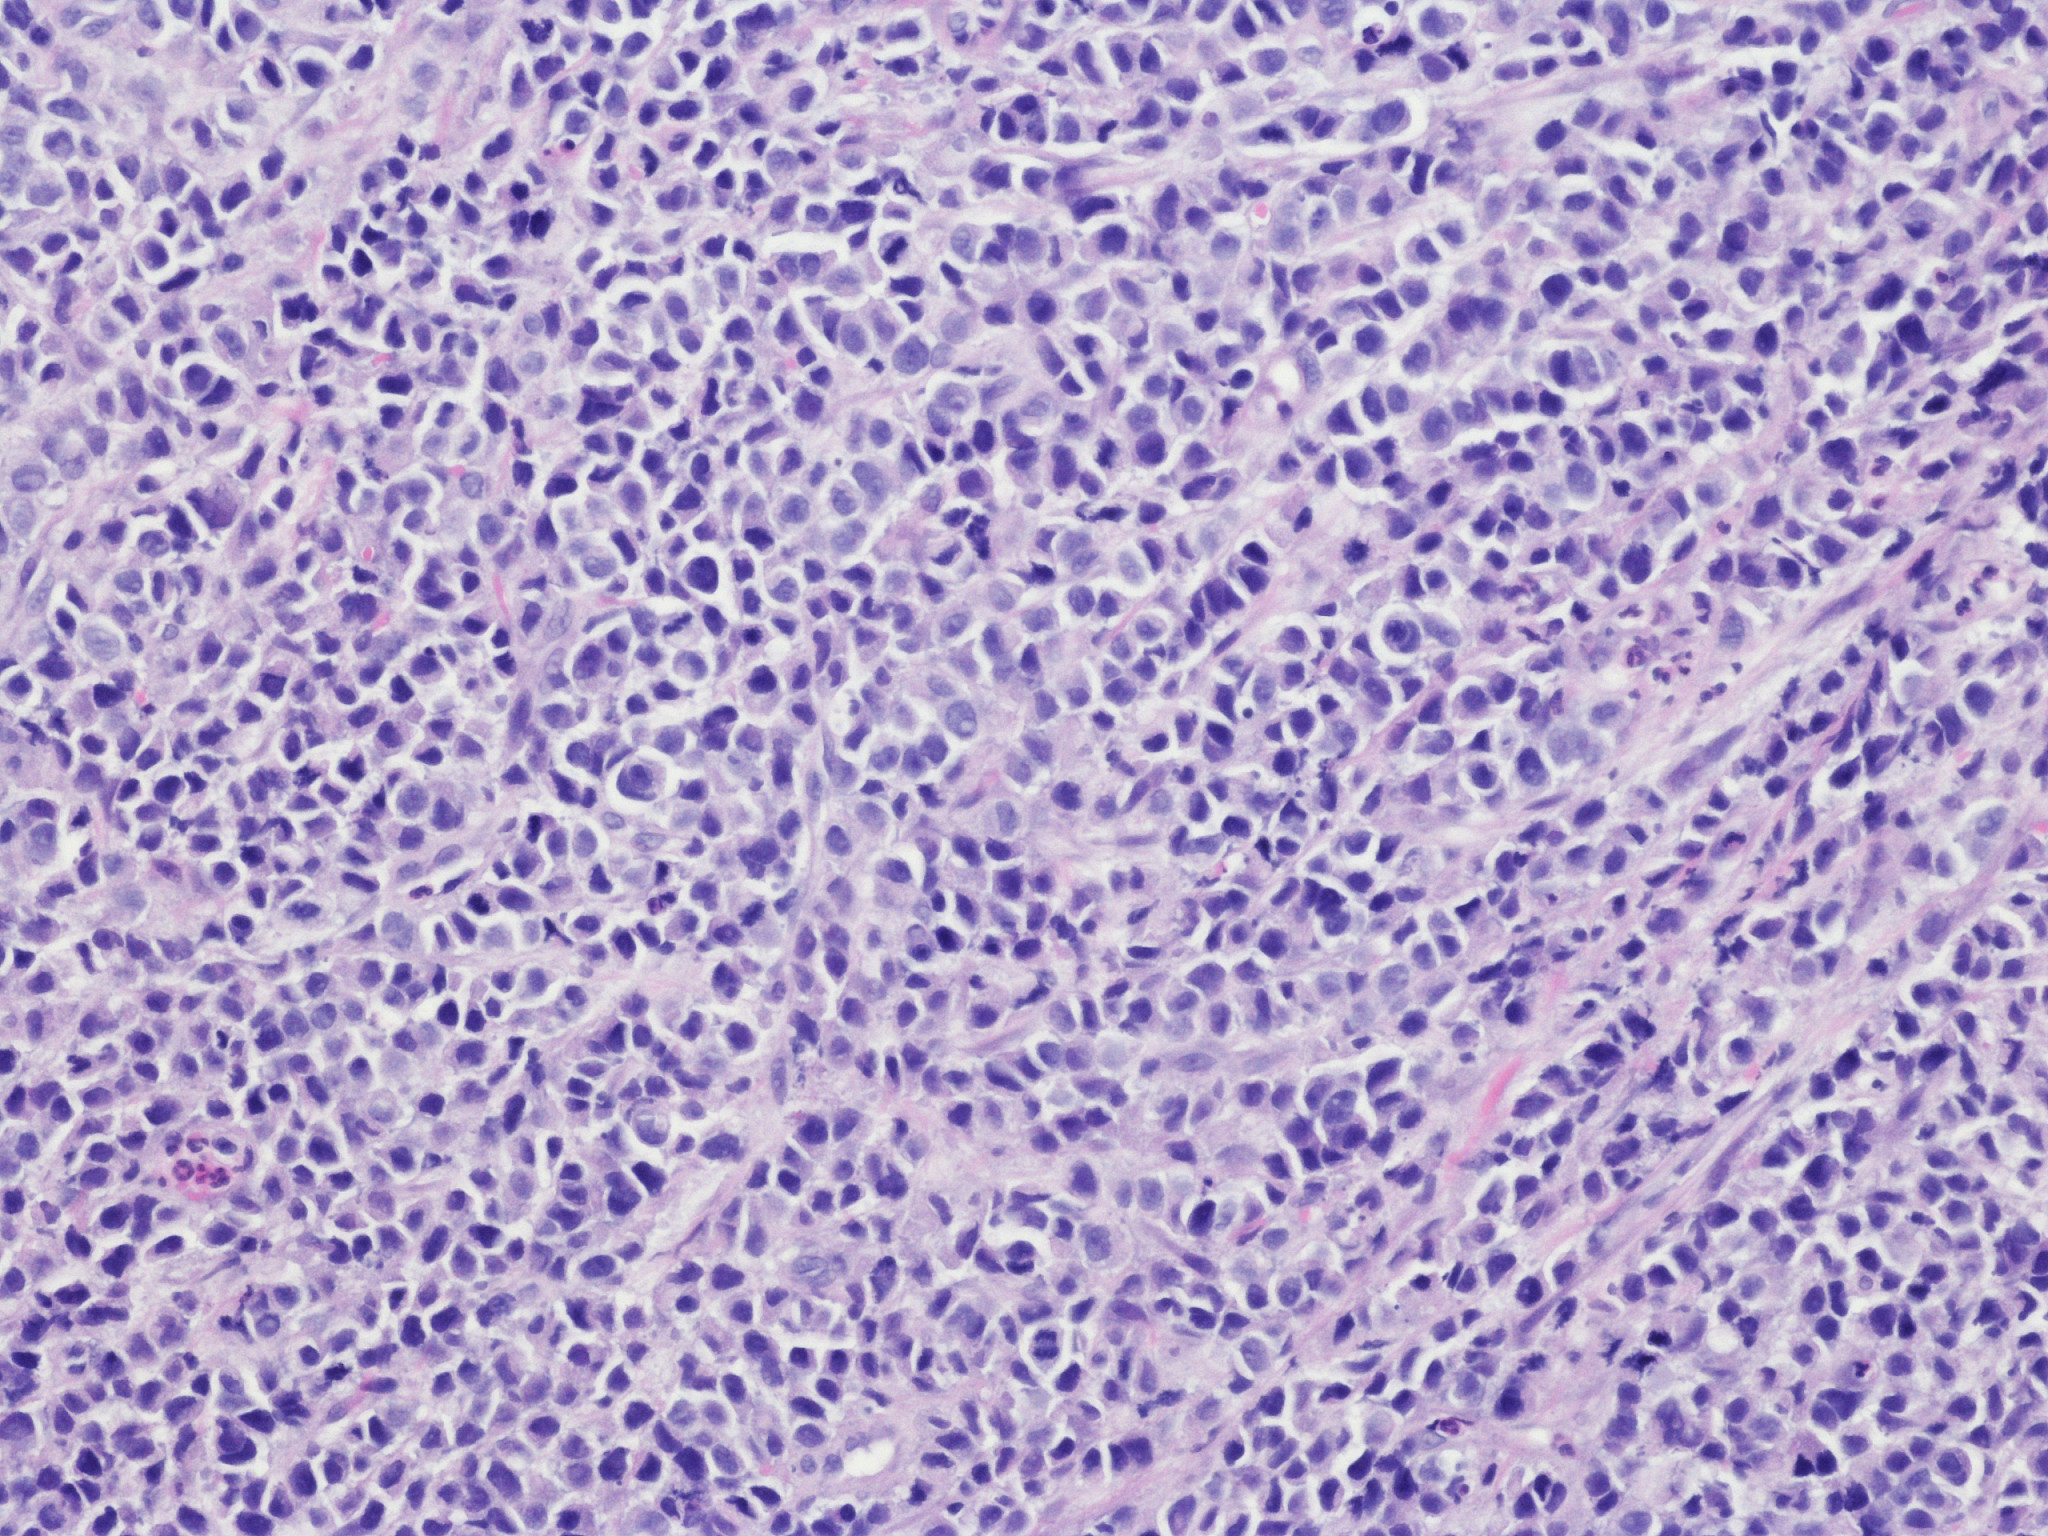
食管癌并发食管胃支气管瘘怎么吃？饮食护理指南

食管癌并发食管胃支气管瘘怎么吃?饮食护理指南
食管癌并发食管胃支气管瘘怎么吃?饮食护理指南
食管胃支气管瘘是食管癌晚期可能出现的严重并发症,指的是食管和胃之间形成了异常通道,导致食物和胃酸误入呼吸道,引发感染和呼吸困难。这种情况下,正确的饮食护理对患者的康复至关重要。以下是一些建议:
1. 优先选择液体饮食:
由于瘘孔的存在,固体食物容易掉入呼吸道,增加感染风险。因此,患者应以易于吞咽消化的液体食物为主,例如:
- 流质食物* 汤类* 果汁* 米糊* 蛋白粉冲剂
2. 少量多餐:
将食物分成多次进食,每次进食量不宜过多,可以有效减少食物误入呼吸道的可能性,减轻消化系统负担。
3. 避免刺激性食物:
辛辣、刺激性食物如辣椒、芥末、酒精等会刺激胃酸分泌,增加瘘孔的通透性,应尽量避免。浓茶、咖啡等也要谨慎饮用。
4. 尝试软糊食物:
如果患者能够耐受,可以逐渐尝试一些软烂易消化的食物,例如:
- 稀饭* 稠粥* 面条* 煮烂的蔬菜* 水果泥
5. 保证高蛋白摄入:
食管胃支气管瘘会导致营养摄取不足,患者需要摄入足够的蛋白质来维持营养平衡和身体修复,建议选择:
- 鱼肉* 禽肉* 蛋类* 豆制品* 牛奶
6. 补充维生素和矿物质:
患者可能由于食物摄取减少而导致维生素和矿物质缺乏,可以在医生指导下适当补充营养补剂,确保营养均衡。
7. 保持健康体重:
食管胃支气管瘘患者常伴有消瘦和营养不良,应尽量保持适当的体重,避免过度消瘦,必要时咨询营养师制定个性化饮食方案。
总结:
食管胃支气管瘘的饮食护理需要格外谨慎,总的来说,应以液体饮食为主,避免刺激性食物,增加蛋白质和营养素的摄入,保持适当的体重。最重要的是,患者需要与医生和营养师保持密切沟通,根据自身情况调整饮食方案,才能更好地控制病情,提高生活质量。
原文地址: https://www.cveoy.top/t/topic/foqS 著作权归作者所有。请勿转载和采集!